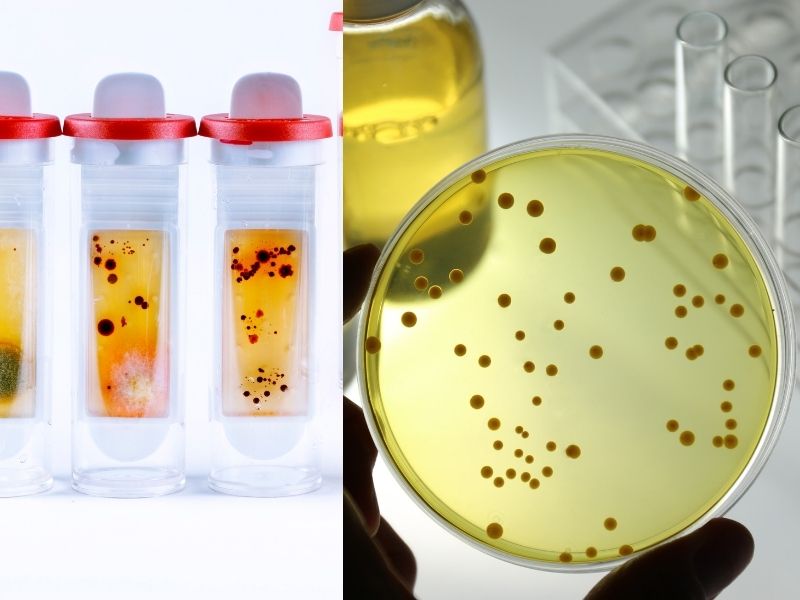

1. Vi khuẩn nhuộm soi là gì?
Vi khuẩn nhuộm soi là một kỹ thuật xét nghiệm vi sinh học thường quy, sử dụng kính hiển vi để quan sát mẫu dịch tiết âm đạo sau khi được xử lý bằng phương pháp nhuộm đặc hiệu (thường là nhuộm Gram). Phương pháp này cho phép bác sĩ phát hiện sự hiện diện và định danh sơ bộ các loại vi khuẩn, nấm hoặc ký sinh trùng gây viêm nhiễm phụ khoa.
Đây là xét nghiệm đơn giản, nhanh chóng, chi phí thấp nhưng mang lại giá trị chẩn đoán cao. Đặc biệt, trong việc phát hiện viêm âm đạo do vi khuẩn, viêm âm đạo do nấm Candida, nhiễm Trichomonas, hoặc rối loạn hệ vi sinh âm đạo.
2. Mục đích của xét nghiệm vi khuẩn nhuộm soi
Xét nghiệm vi khuẩn nhuộm soi là một trong những công cụ chẩn đoán quan trọng và có giá trị cao trong lĩnh vực lâm sàng sản phụ khoa. Phương pháp này không chỉ giúp xác định nguyên nhân gây viêm nhiễm âm đạo một cách nhanh chóng và chính xác, mà còn hỗ trợ bác sĩ trong việc xây dựng phác đồ điều trị phù hợp, cá nhân hóa theo từng tình trạng cụ thể của bệnh nhân.
Cụ thể, xét nghiệm vi khuẩn nhuộm soi cho phép:
-
Phát hiện và nhận diện các vi khuẩn có hại trong âm đạo, đặc biệt là những tác nhân gây bệnh phổ biến như Gardnerella vaginalis, Mobiluncus spp., Trichomonas vaginalis – những vi khuẩn hoặc ký sinh trùng có thể gây ra viêm âm đạo, khí hư bất thường, mùi hôi và cảm giác ngứa rát kéo dài.
-
Đánh giá tình trạng hệ vi sinh âm đạo, xác định mức độ cân bằng giữa lợi khuẩn (như Lactobacillus) và vi khuẩn có hại. Từ đó, giúp bác sĩ chẩn đoán sớm tình trạng mất cân bằng hệ vi sinh (dysbiosis) – yếu tố nguy cơ hàng đầu dẫn đến các đợt viêm âm đạo tái phát và kéo dài.
-
Phát hiện nấm men Candida albicans, nguyên nhân phổ biến gây viêm âm đạo do nấm – một dạng viêm âm đạo rất thường gặp, đặc biệt ở phụ nữ mang thai, người dùng kháng sinh kéo dài hoặc có hệ miễn dịch suy giảm.
-
Xác định chỉ số Nugent – thang điểm vi sinh học được áp dụng trong nhuộm Gram, nhằm đánh giá mức độ rối loạn hệ vi sinh và hỗ trợ chẩn đoán viêm âm đạo do vi khuẩn (Bacterial Vaginosis – BV). Chỉ số này cung cấp căn cứ khách quan và định lượng để đưa ra quyết định lâm sàng hiệu quả.
Nhờ tính ứng dụng rộng rãi và khả năng cung cấp thông tin vi sinh tức thời, xét nghiệm vi khuẩn nhuộm soi hiện được xem là xét nghiệm sàng lọc đầu tay trong chẩn đoán các bệnh lý viêm nhiễm phụ khoa. Đây cũng là một phần không thể thiếu trong quy trình thăm khám định kỳ nhằm bảo vệ sức khỏe sinh sản toàn diện cho phụ nữ.
3. Quy trình thực hiện xét nghiệm vi khuẩn nhuộm soi
Tại Phòng khám Sản – Nhi – Xét nghiệm 18 Starlake, quy trình xét nghiệm vi khuẩn nhuộm soi được thực hiện theo chuẩn mực y khoa nghiêm ngặt, đảm bảo tính chính xác, an toàn và mang lại kết quả tối ưu cho bệnh nhân. Mỗi bước trong quy trình đều được kiểm soát chặt chẽ, từ khâu lấy mẫu cho đến phân tích kết quả, cụ thể như sau:
-
Lấy mẫu bệnh phẩm: Các bác sĩ chuyên khoa Sản phụ khoa tiến hành lấy dịch âm đạo bằng que vô trùng, với thao tác nhẹ nhàng, chính xác, hạn chế tối đa cảm giác khó chịu cho người bệnh. Quy trình này được thực hiện trong môi trường vô khuẩn, tuân thủ tuyệt đối các quy định về kiểm soát nhiễm khuẩn và bảo vệ quyền riêng tư của bệnh nhân.
-
Chuẩn bị tiêu bản: Sau khi thu thập mẫu dịch, kỹ thuật viên tiến hành phết mẫu lên lam kính để tạo tiêu bản. Mẫu sau đó được xử lý bằng phương pháp nhuộm Gram – một kỹ thuật nhuộm màu vi sinh phổ biến trong lâm sàng, giúp phân biệt vi khuẩn Gram âm và Gram dương, đồng thời hỗ trợ quan sát hình thái của các vi sinh vật.
-
Soi kính hiển vi: Tiêu bản nhuộm được đưa vào kính hiển vi quang học có độ phóng đại cao. Bác sĩ hoặc kỹ thuật viên vi sinh sẽ tiến hành phân tích mẫu, tìm kiếm sự hiện diện của các tác nhân gây bệnh như vi khuẩn (ví dụ Gardnerella, Mobiluncus), nấm (Candida), ký sinh trùng (Trichomonas vaginalis) hay các dấu hiệu mất cân bằng hệ vi sinh âm đạo.
-
Đánh giá và trả kết quả: Dựa vào hình thái học, màu nhuộm, mật độ phân bố và đặc điểm cấu trúc của các vi sinh vật được phát hiện, bác sĩ sẽ đưa ra đánh giá sơ bộ và xác định mức độ viêm nhiễm. Kết quả xét nghiệm được trả nhanh chóng, thường trong cùng ngày, giúp rút ngắn thời gian chẩn đoán và can thiệp điều trị.
Với trang thiết bị hiện đại, đội ngũ chuyên môn cao và quy trình vận hành chuẩn hóa, Phòng khám Sản – Nhi – Xét nghiệm 18 Starlake cam kết mang lại trải nghiệm y tế chất lượng, góp phần nâng cao hiệu quả điều trị và bảo vệ sức khỏe phụ khoa cho phụ nữ ở mọi độ tuổi.
4. Khi nào nên thực hiện xét nghiệm vi khuẩn nhuộm soi âm đạo?
Xét nghiệm vi khuẩn nhuộm soi là một phương pháp đơn giản nhưng mang lại giá trị chẩn đoán cao trong việc phát hiện sớm các tác nhân gây viêm nhiễm phụ khoa. Bạn nên chủ động đến khám và thực hiện xét nghiệm nếu xuất hiện một hoặc nhiều dấu hiệu bất thường sau:
-
Khí hư thay đổi bất thường về màu sắc (trắng đục, vàng, xanh…), tính chất (loãng, đặc quánh, có bọt…), hoặc có mùi khó chịu, nhất là mùi tanh nồng – dấu hiệu điển hình của tình trạng viêm âm đạo do vi khuẩn hoặc nhiễm nấm.
-
Mùi hôi vùng kín, đặc biệt rõ rệt sau khi quan hệ tình dục, có thể là biểu hiện của tình trạng nhiễm khuẩn âm đạo (Bacterial Vaginosis) hoặc nhiễm ký sinh trùng như Trichomonas vaginalis.
-
Cảm giác ngứa ngáy, nóng rát hoặc khó chịu ở vùng âm hộ – âm đạo, ảnh hưởng đến sinh hoạt hàng ngày và chất lượng cuộc sống.
-
Đau khi quan hệ tình dục (dyspareunia) – có thể liên quan đến các viêm nhiễm tại niêm mạc âm đạo, cổ tử cung hoặc tình trạng rối loạn hệ vi sinh âm đạo.
-
Rối loạn tiểu tiện như tiểu buốt, tiểu rát – đôi khi là dấu hiệu viêm đường tiết niệu nhưng cũng có thể đi kèm với viêm âm đạo lan rộng.
Bên cạnh các biểu hiện lâm sàng kể trên, xét nghiệm vi khuẩn nhuộm soi còn được chỉ định định kỳ trong thai kỳ để theo dõi sức khỏe phụ khoa của mẹ bầu, giúp phòng ngừa sinh non hoặc nhiễm trùng sơ sinh. Ngoài ra, xét nghiệm này cũng cần thực hiện trước khi tiến hành các can thiệp thủ thuật phụ khoa như soi cổ tử cung, đặt vòng tránh thai, bơm tinh trùng vào buồng tử cung (IUI),… nhằm đảm bảo môi trường âm đạo không bị viêm nhiễm, tạo điều kiện thuận lợi cho thủ thuật và phòng ngừa biến chứng.
Chủ động xét nghiệm khi có dấu hiệu bất thường chính là bước đầu quan trọng trong việc chăm sóc và bảo vệ sức khỏe sinh sản của bạn một cách toàn diện và khoa học.
5. Ưu điểm khi thực hiện xét nghiệm tại Phòng khám Sản – Nhi – Xét nghiệm 18 Starlake
Là địa chỉ uy tín trong lĩnh vực chăm sóc sức khỏe phụ khoa, Phòng khám Sản – Nhi – Xét nghiệm 18 Starlake mang đến trải nghiệm xét nghiệm vi khuẩn nhuộm soi toàn diện – từ quy trình chuyên nghiệp đến chất lượng dịch vụ vượt trội. Những ưu điểm nổi bật giúp phòng khám trở thành lựa chọn tin cậy của đông đảo khách hàng bao gồm:
-
Trang thiết bị y tế hiện đại: Phòng khám được đầu tư hệ thống máy móc và thiết bị xét nghiệm tiên tiến, đặc biệt là kính hiển vi quang học độ phân giải cao, cho hình ảnh tiêu bản sắc nét, hỗ trợ bác sĩ quan sát rõ ràng hình thái vi sinh vật và đưa ra đánh giá chính xác nhất.
-
Đội ngũ bác sĩ chuyên môn cao: Các bác sĩ chuyên khoa Sản phụ khoa có trình độ chuyên môn vững vàng, nhiều năm kinh nghiệm trong chẩn đoán và điều trị các bệnh lý phụ khoa. Bên cạnh đó, đội ngũ luôn lắng nghe, tư vấn tận tâm và đưa ra các phác đồ điều trị cá nhân hóa phù hợp với từng tình trạng cụ thể của người bệnh.
-
Quy trình lấy mẫu nhẹ nhàng, an toàn: Toàn bộ quy trình lấy dịch âm đạo được thực hiện trong môi trường vô khuẩn, sử dụng dụng cụ y tế đạt chuẩn. Bác sĩ thao tác chính xác, nhẹ nhàng, hạn chế tối đa cảm giác khó chịu, mang lại sự an tâm cho người bệnh.
-
Trả kết quả nhanh, hỗ trợ điều trị kịp thời: Nhờ quy trình vận hành khép kín và đồng bộ, kết quả xét nghiệm được trả nhanh chóng – thường trong ngày, giúp bác sĩ sớm đưa ra chỉ định điều trị và bệnh nhân không phải chờ đợi lâu.
-
Bảo mật thông tin tuyệt đối: Thông tin cá nhân và kết quả xét nghiệm của người bệnh được lưu trữ và bảo mật theo tiêu chuẩn y tế quốc tế, đảm bảo quyền riêng tư và sự an toàn trong quá trình chăm sóc sức khỏe.
Với cam kết không ngừng nâng cao chất lượng dịch vụ và đặt sức khỏe bệnh nhân làm trung tâm, Phòng khám Sản – Nhi – Xét nghiệm 18 Starlake chính là địa chỉ lý tưởng cho mọi phụ nữ khi cần kiểm tra và bảo vệ sức khỏe phụ khoa một cách toàn diện và chuyên nghiệp.
6. Lời khuyên từ bác sĩ
Hệ vi sinh âm đạo là một hệ sinh thái tinh vi, nơi các vi khuẩn có lợi – điển hình là Lactobacillus – giữ vai trò kiểm soát độ pH và ức chế sự phát triển của các tác nhân gây hại. Khi sự cân bằng này bị phá vỡ, nguy cơ mắc các bệnh viêm nhiễm phụ khoa như viêm âm đạo do vi khuẩn, nấm, ký sinh trùng… sẽ gia tăng đáng kể.
Do đó, để duy trì môi trường âm đạo khỏe mạnh và phòng tránh viêm nhiễm hiệu quả, chị em phụ nữ cần lưu ý một số nguyên tắc chăm sóc sau:
-
Vệ sinh vùng kín đúng cách: Sử dụng nước sạch hoặc dung dịch vệ sinh dịu nhẹ, tránh thụt rửa sâu vào âm đạo – thói quen dễ làm tổn thương niêm mạc và phá vỡ cân bằng hệ vi sinh tự nhiên.
-
Hạn chế lạm dụng các sản phẩm có chất tẩy rửa mạnh: Dung dịch có độ pH không phù hợp hoặc chứa hóa chất gây kích ứng có thể tiêu diệt vi khuẩn có lợi, tạo điều kiện cho vi khuẩn có hại phát triển.
-
Khám phụ khoa định kỳ 6 tháng/lần: Đây là biện pháp cần thiết để theo dõi sức khỏe sinh sản tổng quát, phát hiện sớm các bất thường dù chưa có triệu chứng rõ ràng.
-
Chủ động thực hiện xét nghiệm vi khuẩn nhuộm soi khi có các biểu hiện nghi ngờ như khí hư bất thường, ngứa rát, mùi hôi… giúp phát hiện chính xác nguyên nhân viêm nhiễm và can thiệp điều trị kịp thời.
Việc duy trì một hệ vi sinh âm đạo cân bằng không chỉ giúp phòng ngừa bệnh lý phụ khoa mà còn góp phần nâng cao chất lượng cuộc sống, bảo vệ sức khỏe sinh sản và tâm lý cho phụ nữ ở mọi độ tuổi.
Như vậy, vi khuẩn nhuộm soi là một công cụ chẩn đoán đơn giản nhưng có độ chính xác cao, giúp phát hiện sớm các tác nhân gây viêm nhiễm phụ khoa. Chủ động thăm khám và thực hiện xét nghiệm khi có dấu hiệu bất thường sẽ giúp chị em bảo vệ tốt sức khỏe sinh sản, tránh biến chứng và duy trì chất lượng cuộc sống. Nếu bạn đang gặp vấn đề hoặc cần tư vấn, đừng ngần ngại liên hệ với Phòng khám Sản – Nhi – Xét nghiệm 18 Starlake để được hỗ trợ kịp thời.
Phòng Khám Sản Nhi Xét Nghiệm BS Kha Trâm CS2Địa chỉ: TT1. K7 – SH18 Khu đô thị Starlake, Xuân La, Tây hồ, Hà Nội.Hotline: 0865 467 969Website: https://sannhi18starlake.vn/ |